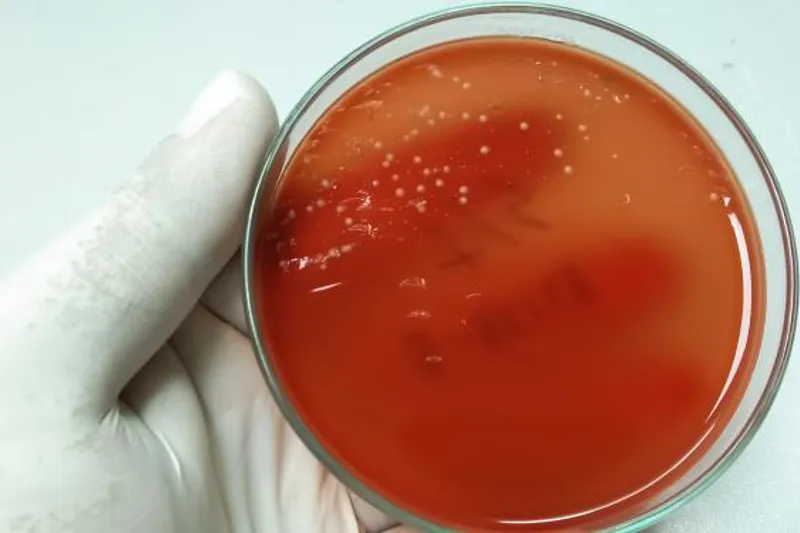

Nedsat aktivitet af streptokokker ved parodontitis
Ny kortlægning af orale streptokokkers aktivitetsniveau viser en nedsat aktivitet af visse typer af streptokokker hos patienter med parodontitis.
De senere år er der sket en nærmest revolutionerende teknisk udvikling inden for mikrobiologien. Med metagenomanalyser kan man påvise tilstedeværelse af arter, der ikke kan dyrkes, og med metatranskriptom-analyser kan man studere aktiviteten af enkelte gener i et givet miljø på et givet tidspunkt.
Forskere fra Odontologisk Institut, Costerton Biofilm Center og Lundbeck Foundation GeoGenetics Centre (Københavns Universitet) har sammen med kolleger fra Singapore og Schweiz anvendt disse teknikker til en kortlægning af orale streptokokkers aktivitetsniveau i prøver fra saliva, tunge og subgingival plak hos 11 patienter med parodontitis og 11 raske kontrolpersoner.
Patienter med parodontitis havde signifikant lavere aktivitet af Streptococcus salivarius, S. parasanguinis, S. oralis, S. infantis og S. gordonii i saliva; på tungen var der signifikant lavere aktivitet af S. salivarius, S. parasanguinis og S. oralis, mens det i subgingival plak kun var S. oralis, der udviste nedsat aktivitet. Dette kunne ifølge forskerne tyde på, at de økologiske forandringer, der sker i plakken ved parodontitis, typisk medfører forøget aktivitet af parodontitisbakterier, men ikke samtidig nedsat aktivitet af streptokokker.
Det var især S. parasanguinis, der havde ændret adfærd hos patienter med parodontitis, idet der var signifikant nedsat aktivitet af hele 18 gener (fx for glykolyse samt biosyntese af peptidoglykan og aminosyrer) fra denne bakterie i saliva fra patienterne. S. parasanguinis påkalder sig særlig opmærksomhed, fordi den er en af de få bakterier, der tilskrives en rolle ved udvikling af såvel caries som parodontitis, og ifølge forskerne kan den påviste høje tilpasningsevne være en del af forklaringen herpå.
Kilde: Belstrøm D, Constancias F, Markvart M, Sikora M, Sørensen CE, Givskov M. Transcriptional activity of predominant streptococcus species at multiple oral sites associated with periodontal status. Front Cell Infect Microbiol 2021;11:752664.